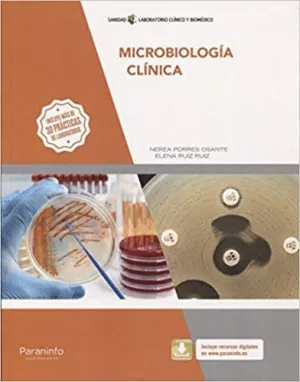

- Editorial:
- PARANINFO, EDICIONES
- Año de edición:
- 2018
- ISBN:
- 978-84-283-4026-7
- Páginas:
- 285
- Encuadernación:
- Rústica
MICROBIOLOGÍA CLÍNICA
ELENA RUIZ RUIZ, NEREA PORRES OSANTE
Este libro está dirigido a los alumnos del Ciclo Formativo de grado superior que conduce a la obtención del título de Técnico Superior en Laboratorio Clínico y Biomédico, perteneciente a la familia profesional de Sanidad. La obra consta de nueve unidades en las que se desarrollan los contenidos requeridos para el aprendizaje del módulo profesional de Microbiología Clínica, según la normativa vigente. Incluye más de 30 prácticas de laboratorio. Microbiología clínica comienza con una sencilla introducción al laboratorio de microbiología. A continuación, se describen los diferentes tipos de microorganismos y las principales técnicas de microscopía empleadas en el diagnóstico clínico y biomédico. Posteriormente, se centra en el diagnóstico e identificación microbiológicos de los cuatro tipos de microorganismos: bacterias, hongos, parásitos y virus. El texto dedica una mayor extensión y profundización a la bacteriología por su gran relevancia en el campo de la microbiología clínica. Asimismo, se dedica una unidad íntegramente al diagnóstico de la resistencia a los antibióticos que tanta trascendencia tiene en la actualidad, tanto en el ámbito hospitalario como en el comunitario. Los contenidos teóricos se acompañan en cada unidad de numerosos esquemas, tablas, dibujos y material fotográfico que hacen más fácil su comprensión y acercan al estudiante al día a día de su futuro entorno laboral. También se incluyen enlaces a páginas web de interés que permiten consolidar o ampliar conocimientos. Al final de cada unidad se podrán repasar los contenidos con un mapa conceptual y poner en práctica los conocimientos adquiridos a través de las numerosas y variadas actividades finales que se ofrecen. También se describen gran cantidad de prácticas de laboratorio, fáciles de realizar en cualquier centro educativo, que ayudarán al futuro técnico a afianzar los conceptos y a alcanzar las destrezas prácticas necesarias en el laboratorio. Además, el libro ofrece una serie de útiles recursos digitales que serán de gran ayuda para facilitar la comprensión del módulo, a través de la ficha web de la obra y mediante un sencillo registro desde la sección de «Recursos previo registro». En definitiva, este libro ofrece un amplio conjunto de herramientas que será de gran ayuda tanto para que el alumno adquiera las competencias requeridas en el laboratorio como para el profesional en activo que precise de una revisión rápida y actualizada, de fácil consulta, sobre la materia.






